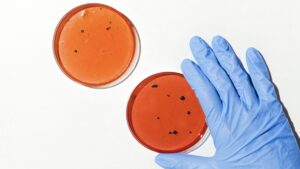

Extreme Overpopulation of Farm Animals
Publication #3
TVD identifies an extreme overpopulation of farm animals and shares the following flash report powered by Google’s Gemini AI engine. Given alternative sources of nutritional content for humans, such as plant-based solutions, the extreme overpopulation of farm animals creates risks to humans that exceed the benefits of industrial animal-based nutritional content.

This is identifiable purely from the costs associated with the cruel practices necessary to maintain animal farm production, including practices specifically designed to protect human health.![]()
Gender-Based Culling of Male Chicks in the Egg Industry:
Since male chicks cannot lay eggs, they’re deemed a ‘waste’ byproduct of the egg industry. These chicks are not bred for meat in the same way as other breeds that gain weight faster. Hundreds of millions of male chicks are culled (killed) each year soon after they hatch.

Gender-Based Culling of Male Calves in the Dairy Industry:
Since male cattle cannot become pregnant, and pregnancy is necessary to produce milk, male calves are slaughtered at a young age for beef or become a ‘waste’ byproduct of the dairy industry. Millions of calves (cow babies) are killed annually for beef or disposal.
Disease & Population Control:
Each year, millions of farm animals are killed in order to prevent the spread of contagious diseases to other farm animals and to humans. Farm animals that are ‘mature, yet idle,’ injured, or environmentally endangered are also killed by the millions annually. They are “depopulated.”
Despite these necessary, yet foreseeable and drastic measures to control the spread of disease, industrial agriculture often fails to protect humans from animal-originated diseases. Disease-causing bacteria harmful to humans, such as Salmonella and E. coli, live in the intestines of livestock and wildlife. Rainfall and ground surface runoff can wash livestock and wildlife feces containing disease into rivers, streams, ponds, and even irrigation canals.
